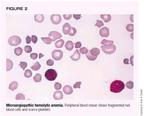

Though not as deadly as it once was, HUS remains a serious threat to young children, with a real risk of dangerous complications. Continuing outbreaks caused by E coli O157:H7 highlight the need for accurate diagnosis, intensive supportive care, and effective prevention.
Though not as deadly as it once was, HUS remains a serious threat to young children, with a real risk of dangerous complications. Continuing outbreaks caused by E coli O157:H7 highlight the need for accurate diagnosis, intensive supportive care, and effective prevention.
The hemolytic uremic syndrome (HUS) is one of the most frequent causes of acute renal failure in children. The commonest form of HUS seen in children is associated with infection, most often Escherichia coli O157:H7 in the United States. While mortality has improved dramatically in recent decades, HUS can still be a devastating illness, as illustrated by recent highly publicized epidemics and the case described (see "The perilous course of HUS: A case study").

After reviewing this article the physician should be able to:

HUS is defined by the triad of acute renal failure, thrombocytopenia, and microangiopathic hemolytic anemia. Gasser and colleagues first described HUS in 1955 when they reported five children who died in the acute phase of the illness.1 While the causes of HUS are many (Table 1), a diarrheal illness precedes the syndrome in 90% of cases. This typical postdiarrheal form caused by infection with particular strains of E coli is by far the type of HUS that the primary care physician is most likely to encounter.

Infectious
With a diarrheal prodrome
Verotoxin-producing E coli
(especially O157:H7, also other
serotypes)
Shigella dysenteriae type 1
Other bacteria (Aeromonas,
Citrobacter, Campylobacter)
Streptococcus pneumoniae
Human immunodeficiency virus 1
Noninfectious
Idiopathic (atypical, not associated
with diarrhea)
Inherited
Autosomal recessive
Autosomal dominant
Factor H deficiency
Inborn error of cobalamin metabolism
Drug-related
Oral contraceptives
Cyclosporine A, tacrolimus
Mitomycin
Cancer chemotherapy-associated
Associated with pregnancy
Associated with malignant hypertension
Associated with malignancies
Associated with transplantation (kidney, liver, heart, bone marrow)
The enterohemorrhagic E coli (EHEC) are closely related to the enteropathogenic E coli that are a significant cause of watery infantile diarrhea worldwide. The EHEC, however, have additional virulence factors that produce hemorrhagic colitis. The prototypical EHEC is E coli O157:H7. This organism was first recognized as a pathogen in 1982 during two outbreaks of hemorrhagic colitis traced to contaminated hamburgers.2 There have been more than 100 outbreaks of E coli O157:H7 disease in the US since 1982, although the majority of infections occur sporadically.
The incubation period from exposure to EHEC to the onset of diarrhea is usually about three to four days (range one to 12 days).3,4 The diarrhea generally starts out nonbloody and accompanied by abdominal cramps, tenesmus, and vomiting. Fever is not a prominent feature in most cases. In 72% of patients the diarrhea turns bloody after one to two days and lasts another five to seven days. It tends to persist longer in children than adults. Infection may be asymptomatic. Approximately 95% of cases of hemorrhagic colitis resolve completely. The remaining 5% of patients go on to develop HUS.
E coli O157:H7 is recognized as the major cause of HUS as well as hemorrhagic colitis in the US.5,6 Other EHEC serogroups also cause HUS in this country and around the world, notably O111 and O103 in Europe and serotype O111:H in Australia. In Southeast Asia HUS occurs more commonly following infection by Shigella dysenteriae, type 1.3
Like hemorrhagic colitis, HUS occurs mainly in the summer months. HUS strikes children between 6 months and 4 years of age with a peak between 1 and 2 years.7 It has a predilection for children of families of higher socioeconomic standing, thought to be related to dietary habits.8 HUS has a wide geographic distribution. In North America it occurs more commonly in the northern US and Canada. Outbreaks appear to have increased since the 1950s.4
Healthy cattle are the major reservoir of E coli O157:H7 with a prevalence of between 0.1% and 16%, but the bacterium can be found in the feces of geese, sheep, horses, dogs, seagulls, goats, and deer as well.4 E coli O157:H7 has been found in up to 3.7% of fresh samples of beef, pork, poultry, and lamb in retail outlets in the US and Canada. Fecal material containing E coli O157:H7 contaminates the surface of beef during slaughtering. Thorough cooking kills surface bacteria on slabs of meat. In preparing ground beef, however, bacteria contaminating the surface can be internalized and may survive cooking if a sufficient internal temperature is not achieved. Undercooked ground beef accounts for the greatest number of foodborne infections.
E coli O157:H7 also has been identified in raw milk, cheese, yogurt, mayonnaise, fermented sausage, cooked maize, lettuce, seed sprouts, and unpasteurized cider. Fruits and vegetables are increasingly implicated in cases of E coli O157:H7 infection. E coli O157:H7 also has been transmitted through contaminated drinking water, contact with contaminated water at beaches and pools, person- to-person contact, and direct contact with animals.
The infectious dose of E coli O157:H7 is very low. As few as 50 viable bacteria present in salami have been associated with an outbreak.4 About 50% of close contacts of patients with HUS will have gastroenteritis, asymptomatic fecal shedding of toxin, or seroconversion.
The virulence of the enterohemorrhagic E coli is determined by such properties as adherence factors encoded on the bacterial chromosome. Key components include intimin, a bacterial outer membrane protein encoded by the eaeA gene, which is involved in initial adherence to the gut wall, and tir, the translocated intimin receptor encoded by the tir gene, which is secreted by the bacterium and inserted into the host enterocyte cell membrane. These factors allow the bacterium to adhere to enterocytes and avoid expulsion. They produce characteristic attaching and effacing lesions consisting of effacement of intestinal villi and disruption of the brush border. The lesions induce water and electrolyte lossthat is, diarrhea.
E coli O157:H7 and related serotypes do not typically invade the host. Their close attachment to the epithelium, however, promotes the delivery of a toxin, verotoxin (VT), to the mucosa where it is transported by the epithelial cells from the apical to the basolateral surface by transcytosis. Once in the mucosa, verotoxin itself causes the microvascular injury that leads to thrombosis, hemorrhage, and necrosis, manifested clinically as bloody diarrhea. Damage to the gut wall, increased permeability of the bowel, or direct adherence of the bacteria to the bowel wall facilitates toxin absorption from the GI tract. Besides its local effects, systemically absorbed toxin can produce widespread injury.
In 1977 it was reported that certain strains of E coli associated with human diarrheal illness produced a cytopathic toxin when grown on vero cells (green monkey kidney cells).9 In 1985, Karmali and colleagues found an association between classical HUS and certain strains of E coli producing a Shiga- like toxin.10 It turned out that these toxins were one and the same and have since been referred to interchangeably as verotoxins or Shiga-like toxins. There are two main subtypes, VT1 and VT2, which itself has several variants (VT2c and VT2e).5
The genes encoding the verotoxins are carried extrachromosomally on bacteriophage DNA. They are closely related to Shiga toxin produced by S dysenteriae type 1, though the gene for this is located on the bacterial chromosome itself. A particular bacterium can produce VT1 or VT2 or both, or more than one type of VT2. Rarely, three different toxins are produced at one time. Most E coli O157:H7 strains produce VT2. From 25% to 80% also produce VT1. HUS is often associated with VT2 and occasionally with VT1 or VT2c alone or in combination. VT2c tends to be less cytopathic than VT1 but causes more GI pathology. VT1 is more often produced by non-O157 serogroups such as O111 and O26.
The verotoxin/Shiga toxin family consists of an enzymatically active A-subunit and five receptor binding B-subunits.5 Neutralization depends on antibody to the B-subunit. The A-subunit of Shiga toxin and VT1 differ by a single amino acid while the B-subunits are identical. They are thus cross- neutralized by antiserum. There is only 60% DNA homology for the A- and B-subunits between Shiga toxin/VT1 and VT2. It is the B-subunit, through different receptor binding affinity, that confers the differing cytotoxic potential of the toxin variants.
The receptor for Shiga toxin and all the verotoxins, except VT2e, is globotriaosyl ceramide (GB3).11 GB3 is a neutral glycolipid found to varying degrees in the membranes of eukaryotic cells. It is identical to the Pk antigen on erythrocytes, CD77 on germinal center B lymphocytes, and the Burkitt's lymphoma antigen. Each B-subunit of verotoxin binds to the carbohydrate moiety of up to three Gb3 molecules (Figure 1).

Endocytosis of the verotoxin/Gb3 complex occurs via clathrin-coated pits. Once taken up into the cell, the toxin is transported to the Golgi network.5 The A-subunit is cleaved into an enzymatically active A1 portion and an A2 portion that remains bound to the B-subunits. A1 is transported from the Golgi network to the rough endoplasmic reticulum. Here it cleaves ribosomal RNA and prevents transfer-RNA binding, thus inhibiting protein synthesis and leading to cell death. It has also been suggested that the B-subunit alone may be involved in inducing apoptosis of cells. Induction of cytokines and adhesion molecules is probably involved in the pathogenesis of HUS as well.
Why is renal injury so prominent in children with HUS? The human kidney contains high levels of Gb3, the receptor for verotoxin, primarily in the cortex. Gb3 is expressed on renal epithelial, endothelial, and mesangial cells. Human renal endothelial cells, in particular, express high constitutive levels of Gb3. VT1 can be shown to bind to the glomeruli of infants, but not adults, in vitro.12 Binding decreases after 2 years of age. VT1 also binds to collecting ducts and distal convoluted tubules adjacent to glomeruli in children and adults. In vitro studies have demonstrated that renal tubular cells are very sensitive to the effects of verotoxins as well.13 The age-related difference in glomerular binding of verotoxin may explain the severity of renal injury in children compared to adults. Age-related differences in infection with E coli O157:H7 and complications could imply a role for immunity. Protective immunity has not been clearly demonstrated in humans, however.
After several days of diarrheal illness, patients suffering from verotoxin-producing E coli colitis that progresses to full-blown HUS suddenly develop pallor and often prostration. Cases of HUS following urinary tract infection caused by these organisms also have been reported.14 Signs and symptoms of HUS often develop even as the diarrhea seems to be improving, about one week (range two to 14 days) after the onset of illness. Patients may present with or quickly develop edema, oliguria, or anuria. Oliguric renal failure develops in 60% of patients with HUS, and 50% of these require dialysis.
Hypertension, abdominal tenderness, and neurologic symptoms including irritability, altered level of consciousness, seizures, hallucinations, paresis, posturing, or blindness may occur. Five percent to 20% of patients develop seizures and coma. Such severe neurologic findings are associated with increased mortality. Central nervous system signs and symptoms may be related to hypertension, electrolyte abnormalities (especially hyponatremia), or CNS microthrombi. While CNS symptoms are common, signs and symptoms of renal failure dominate the clinical picture in typical HUS.
Abdominal findings may be caused by pancreatitis, rectal prolapse, intestinal obstruction from stricture, intussusception, gangrene, or liver injury in addition to the primary colitis. Cardiomyopathy, cardiac aneurysm, and myocarditis can occur. Congestive heart failure may result from myocardial involvement, volume overload, or anemia. Acute respiratory distress syndrome may develop. Pathologically, evidence of microangiopathy is seen with microthrombi and ischemic changes occurring in the affected organs.15
Though partial forms of HUS can occur, laboratory studies usually demonstrate the classic triad. Moderate to severe anemia is always present with evidence on peripheral blood smear of schistocytes, burr cells, helmet cells, spherocytes, and other red cell fragments (Figure 2). This hemolytic anemia may be associated with increased bilirubin and lactic dehydrogenase levels, decreased haptoglobin, and an increased reticulocyte count. The Coombs' test is negative unless HUS is caused by infection with Streptococcus pneumoniae. Thrombocytopenia ranging from mild to severe is seen. The life spans of infused red cells and platelets are decreased. There may be leukocytosis with a shift to the left.
Uremia is often present as indicated by elevated urea nitrogen and creatinine levels. Electrolyte abnormalities may include hyponatremia, hyperkalemia, metabolic acidosis, and hyperphosphatemia. Cardiac enzymes may be elevated in the face of cardiac involvement. Serum glucose, amylase, and lipase may be elevated if the pancreas is involved, although increases in pancreatic enzymes also can result from significant renal failure. Hematuria, proteinuria, pyuria, and casts are often present on urinalysis.
The characteristic pathologic lesion is thrombotic microangiopathy affecting the glomeruli. Glomeruli are variably enlarged and the glomerular capillary walls are thickened with narrowing of the capillary lumens by swollen endothelial cells and accumulation of a fluffy, amorphous material in the subendothelial space (Figure 3). Among the earliest changes seen in the kidney are a leukocytic infiltrate. Microthrombi may be present, causing occlusion of glomerular capillary loops. There may be focal necrosis of glomeruli. Patchy cortical necrosis and tubulointerstitial injury may be present. Electron microscopy shows a fluffy amorphous material separating the glomerular endothelial cells from the basement membrane.16 Microthrombi may be found in the lungs, heart, liver, adrenal glands, brain, thyroid, pancreas, thymus, lymph nodes, and ovaries.

In contrast to renal biopsy specimens from patients with typical diarrhea-associated HUS, specimens in atypical HUS cases show variable glomerular changes. The prominent histopathologic finding is extensive proliferation of the endothelium and smooth muscle cells of extraglomerular arterioles, as shown in Figure 3.17
Risk factors for development of HUS among children infected with EHEC include younger age, infection with a VT2-producing E coli, use of antimotility drugs, and, perhaps, the use of antibiotics. An elevated white blood cell count at onset of disease is a poor prognostic indicator, apparently related to the severity of the inciting infectious process. Patients with prolonged diarrhea, colonic gangrene, and rectal prolapse likewise tend to do poorly.18 Only 60% of patients with prolonged anuria requiring dialysis for more than eight days recover normal renal function, and those requiring dialysis for more than 28 days never appear to recover normal function. Severe hypertension and persistent proteinuria beyond one year predict a poor long-term renal outcome. Even children who were never anuric and some who were never oliguric, however, may develop chronic renal disease in the long-term.19 Severe CNS involvement is strongly associated with increased mortality in the acute phase.18 Adults with typical HUS fare worse than children.
Mortality from typical diarrhea-associated HUS is now less than 5%.20 CNS complications are responsible for up to 47% of the deaths seen in HUS.3 Up to 50% of patients have long-term sequelae such as persistent proteinuria, decreased renal function, hypertension, cholelithiasis, colonic stricture, chronic pancreatitis, diabetes mellitus, and neurologic disorders including mental retardation, seizures, focal motor deficits, optic atrophy, cortical blindness, and learning and behavioral problems.4
Late renal histologic findings in HUS include diffuse glomerulosclerosis, focal segmental glomerulosclerosis, tubular atrophy, and interstitial fibrosis. These persistent renal disorders reflect damage from an acute insult rather than ongoing thrombotic angiopathy. About 3.5% of patients progress to end-stage renal disease requiring chronic dialysis or renal transplantation after an average of 10 years.7 Recurrence of disease is uncommon in patients who receive a kidney transplant for end-stage renal disease resulting from typical diarrhea- associated HUS.
E coli O157:H7 can be detected by isolating the organism from stool culture. The yield is greater than 90% during the first week of diarrheal illness but falls off to about 30% beyond day 6.21 While some labs automatically screen for E coli O157:H7 on any grossly bloody stool sample, not all do, and the fact that this pathogen is being considered should always be noted on the requisition. About 10% of patients have nonbloody diarrhea, and a small group does not have a diarrheal prodrome at all even though they have evidence of infection with verotoxin-producing E coli.20 Thus, a high index of suspicion should be maintained, especially during outbreaks.
E coli O157:H7 is a lactose-fermenting, gram-negative rod and therefore indistinguishable from other E coli on traditional media. Unlike 80% of other E coli, however, it does not ferment D-sorbitol well, and can be detected when grown on McConkey agar containing this compound. Unfortunately, other verotoxin-producing serotypes do ferment D-sorbitol and thus are not identified by this screening. A high index of suspicion must be maintained in the absence of tests confirming the presence of E coli O157:H7.
Free fecal verotoxin (or Shiga- like toxin) can be detected for a longer period than the actual bacterium in about 50% of cases.10 The yield for both the fecal toxin and the bacterium falls off rapidly, however, and it pays to perform these tests as early in the course of the disease as possible. Antibodies to verotoxin-producing organisms are detectable for several weeks after onset of disease, and serologic testing can aid in diagnosis. Indeed, when all three methods of detectionisolation of the pathogen, detection of verotoxin, and serologywere used in a study of North American patients with diarrhea-associated HUS, evidence for verotoxin-producing organisms was found in 75% of cases.10
Optimal management of diarrhea-associated HUS has been confused in the past by failure to distinguish typical HUS from atypical forms of HUS and thrombotic thrombocytopenic purpura (TTP). No specific therapy exists for typical diarrhea-associated HUS. Acute mortality was greater than 30% before 1970 but has since fallen to below 5% because of improvements in supportive care. They include close attention to fluid and electrolyte abnormalities, blood pressure control, nutritional status, and uremia. Dialysis should be instituted when renal failure is progressive or prolonged or medical management cannot control the biochemical milieu (Table 2). Because of the potential for rapid deterioration in the clinical status of children with HUS, early consideration should be given to referral to a tertiary care center with pediatric intensive care and pediatric dialysis capabilities (Table 3).
Progressive uremia
Volume overload not responsive to medical management (diuretics, fluid restriction)
Need for transfusion or nutrition in the face of oliguria or anuria
Electrolyte imbalances not responsive to medical management
Metabolic acidosis not responsive to medical management
Removal of dialyzable factors involved in the pathogenesis of HUS (controversial)
Severe or worsening hemolytic anemia
Severe or worsening thrombocytopenia
Oliguria or anuria
Rising BUN or creatinine
Significant electrolyte abnormalities or metabolic acidosis
Hypertension
Extrarenal organ involvement
The use of antibiotics is controversial. It has been suggested that they may worsen the course of HUS by releasing verotoxin and LPS from lysed bacteria and altering the gut flora.7 In vitro experiments have suggested that trimethoprim-sulfamethoxazole and quinolone antibiotics may even increase verotoxin production.6,22 A recent prospective study demonstrated an increased risk of developing HUS in children with E coli O157:H7 infection treated with antiobiotics.23 Some Japanese studies, however, have suggested that treatment of E coli O157:H7 colitis with fosfomycin within the first two days of illness might prevent progression to HUS.24 For now, given the continued controversy, the recommendation is to avoid using antibiotics.
The evidence against using GI antimotility agents in treating HUS is more solid. They are known to increase the risk for development of toxic megacolon or progression from hemorrhagic colitis to HUS and should be avoided.4
Supportive care includes judicious transfusion of packed red cells for severe anemia and platelet transfusion for active bleeding or in the event that severe thrombocytopenia necessitates an invasive procedure. Indiscriminate platelet transfusion may exacerbate platelet consumption and thrombus formation. Patients should be monitored for evidence of involvement of other organs and appropriate support instituted as needed. Plasma infusion, plasma exchange, steroids, antiplatelet agents, anticoagulants, and intravenous immunoglobulins do not appear to be effective in typical diarrhea-associated HUS.
Trials are currently under way to study the effect of verotoxin binders on the course of E coli-associated hemorrhagic colitis and its progression to HUS.25 As mentioned above, the cellular receptor for verotoxin contains a trisaccharide that is identical to the Pk blood group antigen. The Pk trisaccharide has been chemically linked to a nonabsorbable silicate carrier and administered to patients with either E coli O157:H7 colitis or early HUS in an attempt to soak up free toxin in the GI tract. It appears that treatment very early in the course of the colitis may decrease the risk of progression to HUS. Later treatment may not be as effective, perhaps because of the degree of damage already inflicted by circulating verotoxin. Further studies are needed to determine the place of this therapy in the treatment of patients with HUS, but it is clear that more rapid means of detecting E coli O157:H7 infection are prerequisites to attempting early intervention.
Prevention is clearly the key to avoiding the vast majority of cases of HUS. The primary measure is thorough cooking of meat to a core temperature of 155° F (68° C) or until the meat appears gray or brown throughout and the juices run clear. Fruits and vegetables should be washed well before being eaten. Water used for drinking and recreation should be treated, and milk and cider should be pasteurized.
Good hand washing interrupts person-to-person transmission. It is recommended that children with stool positive for E coli O157:H7 be kept out of day care until at least two negative stool cultures have been documented.4 Asymptomatic infection with E coli O157:H7 is common in household contacts of children with HUS.26 Siblings should be monitored closely for signs and symptoms of colitis or HUS and, if present, stool should be cultured and further evaluation instituted. While a consensus does not exist, household contacts who are food handlers or child-care or elder-care workers should probably be kept out of work until a stool culture is documented to be negative. Likewise, asymptomatic siblings who attend day care should probably be kept home until a negative stool culture is documented. Vaccines containing the O157-specific polysaccharide conjugated to carrier protein for humans are under investigation.
Changing cattle feed from a grain-based diet to a hay diet for several days prior to slaughter has been shown to decrease the acidity within the bovine gut, which in turn interferes with selection for the acid-resistant EHEC within the intestinal tract.27 Irradiation of meats should eliminate contaminating bacteria.
Atypical HUS occurs without the characteristic diarrheal prodrome that is seen with typical HUS caused by verotoxin-producing organisms. HUS or related syndromes can occur with several different disorders as noted in Table 1.
The idiopathic atypical diarrhea-negative forms of HUS are a heterogeneous group. They typically have an insidious onset but are often preceded by a vague flu-like illness. Some cases of atypical HUS reported in the literature may actually be cases of TTP (see below). Atypical HUS is fairly uncommon in childhood and shows no seasonal pattern. Recurrences are common, and mortality is high (26%).28 Chronic renal sequelae also are common and include persistent proteinuria, renal insufficiency, and hypertension.28,29 End-stage renal disease occurs in up to 42% of patients.28
In patients progressing to end-stage renal failure, recurrence of atypical HUS is reported in 10% to 50% of those who receive kidney transplants. Recurrence in the transplanted kidney is more likely in patients who had a recurring course during their initial disease.28,29 Two-year graft survival is poor at only 35%.18 Treatment with plasmapheresis or plasma exchange may help.
Both autosomal recessive and autosomal dominant inherited forms of HUS have been described.30 Together these account for less than 5% of cases. The recessive form generally begins in childhood, tends to recur, and has a high mortality. It is suspected if HUS occurs more than one year apart in siblings. The dominant form generally appears in adulthood, tends to recur, and has a mortality rate approaching 90%. Some families have been reported to have a deficiency of Factor H of the alternative pathway of complement.31
HUS has also been described in association with S pneumoniae infection.32 It is proposed that the pneumococcal neuraminidase cleaves N-acetylneuraminic acid to form cell-surface glycoproteins exposing the cryptic T (Thomsen- Friedenreich) antigen present on red blood cells, platelets, and glomeruli. Anti-T IgM is present in most human plasma and leads to hemolytic anemia, thrombocytopenia, and renal failure.
The median age of onset is 16 months.33 A little more than half of patients develop evidence of HUS within 72 hours of presentation with pneumoccocal illness while the rest already have HUS at the time of presentation. Most patients require dialysis. Mortality is high. In our experience, 50% of patients with pneumococcal HUS progress to end-stage renal failure.
The distinction between HUS and TTP is not always clear cut. Both manifest with a microangiopathic hemolytic anemia and thrombocytopenia,34 but TTP tends to affect adults, and CNS involvement is its most prominent feature in contrast to the central involvement of the kidney in HUS. Relapses are common in TTP, and it often recurs in kidney transplants. Mortality is higher than in diarrhea-associated HUS.
Recent research has distinguished HUS from both chronic familial relapsing TTP and acute nonfamilial, nonrelapsing TTP by the absence of a specific von Willebrand factor-cleaving protease activity in the plasma of patients with TTP. In the chronic form of TTP, the lack of protease activity results from an inherited gene mutation that leads to absence or inactivation of the protease itself.35 In the acute form, a protease blocking autoantibody is present.36 In HUS, protease activity is normal. The differences in protease activity may explain why plasma infusion or exchange can benefit patients with TTP but not diarrhea- associated HUS. It is hoped that this research will pave the way for a clinical test to diagnose questionable cases.
Critical goals for future research into HUS include developing better methods for preventing typical HUS and gaining a better understanding of the pathogenesis of the atypical forms that might lead to better treatment and perhaps prevention.
REFERENCES
1. Gasser VC, Gautier E, Steek A, et al: Hamolytisch-uramische syndrome: Bilaterale nierenrindennekrosen bei akuten erwrbenen hamolytischen anamien. Schweiz Med Wochenschr 1955;38/39:905
2. Riley LW, Remis RS, Helgerson SD, et al: Hemorrhagic colitis associated with a rare Escherichia coli serotype. N Engl J Med 1983;308:681
3. Robson WLK, Leung AKC, Kaplan BS: Hemolytic uremic syndrome. Curr Prob Pediatr 1993;23:16
4. Mead PS, Griffin PM: Escherichia coli O157:H7. Lancet 1998;352:1207
5. Arbus GS: Association of verotoxin-producing E coli and verotoxin with hemolytic uremic syndrome. Kidney Int 1997;51(suppl 58):S9 I
6. Remuzzi G, Ruggenenti P: The hemolytic uremic syndrome. Kidney Int 1995;47:2
7. Siegler RL, Pavia AT, Christofferson RD, et al: A 20-year population-based study of postdiarrheal hemolytic uremic syndrome in Utah. Pediatrics 1994;94:35
8. Robson WLM, Fick GH: Increased incidence of haemolytic uraemic syndrome in children who have a father who is either a physician or a lawyer. Pediatr Nephrol 1990;4:576
9. Konowalchuk J, Speirs JI, Stavric S: Vero response to a cytotoxin of Escherichia coli. Infect Immun 1977;18:775
10. Karmali MA, Petric M, Lim C, et al: The association between idiopathic hemolytic uremic syndrome and infection by verotoxin-producing Escherichia coli. J Infect Dis 1985;151:775
11. Lingwood CA: Verotoxins and their glycolipid receptors. Adv Lipid Res 1993;25:189
12. Lingwood CA: Verotoxin-binding in human renal sections. Nephron 1994;66:21
13. Hughes AY, Stricklett PIC, Kohan DE: Cytotoxic effect of Shiga toxin-1 on human proximal tubule cells. Kidney Int 1998;54:426
14. Starr M, Bennett-Wood V, Bigham AY, et al: Hemolytic uremic syndrome following urinary tract infection with enterohemorrhagic Escherichia coli: Case report and review. Clin Infect Dis 1998;27:310
15. Upadhyayak K, Barwick K, Fishaut M, et al: The importance of nonrenal involvement in hemolytic uremic syndrome. Pediatrics 1980;65:115
16. Habib R, Levy M, Gagnadoux M-F, et al: Prognosis of the hemolytic uremic syndrome in children. Adv Nephrol 1982;11:99
17. Renaud C, Niaudet P, Gagnadoux W, et al: Haemolytic uraemic syndrome: Prognostic factors in children over 3 years of age. Pediatr Nephrol 1995;9:24
18. Kaplan BS, Meyers KE, Schulman SL: The pathogenesis and treatment of hemolytic uremic syndrome. J Am Soc Nephrol 1998;9:1126
19. Siegler RL, Milligan W, Burningham TH, et al: Long-term and prognostic indicators in the hemolytic uremic syndrome. J Pediatr 1991;188:195
20. Repetto HA: Epidemic hemolytic uremic syndrome in children. Kidney Int 1997;52:1708
21. Tarr PI, Neill MA, Clausen CR, et al: Escherichia coli O157:H7 and the hemolytic uremic syndrome: Importance of early cultures in establishing the etiology. J Infect Dis 1990;162:553
22. Yoh M, Frimpong EK, Voravuthikunchai SP, et al: Effect of subinhibitory concentrations of antimicrobial agents (quinolones and macrolide) on the production of verotoxin by enterohemorrhagic Escherichia coli O157:H7. Can J Microbiol 1999;45:732
23. Wong CS, Jelacic S, Habeeb RL, et al: The risk of the hemolytic uremic syndrome after antibiotic treatment of Escherichia coli O157:H7 infections. N Engl J Med 2000;342:1930
24. Ikeda K, Ida O, Kimoto K, et al: Effect of early fosfomycin treatment on prevention of hemolytic uremic syndrome accompanying Escherichia coli O157:H7 infection. Clin Nephrol 1999;52:357
25. Trachtman H, Christen E: Pathogenesis, treatment, and therapeutic trials in hemolytic uremic syndrome. Curr Opin Pediatr 1999;11:162
26. Heuvelink AE, Van de Kar NC, Van Der Velden TJ, et al: Verocytotoxin-producing Escherichia coli infection in household members of children with hemolytic uremic syndrome in the Netherlands. Pediatr Infect Dis J 1999;18:709
27. Diez-Gonzalez F, Callaway TR, Kizoulis MG, et al: Grain feeding and the dissemination of acid-resistant Escherichia coli from cattle. Science 1998;281:1666
28. Neuhaus TJ, Calonder S, Leumann EP: Heterogeneity of atypical haemolytic uraemic syndromes. Arch Dis Child 1997;76:518
29. Siegler RL, Pavia AT, Hansen FL, et al: Atypical hemolytic uremic syndrome: A comparison with postdiarrheal disease. J Pediatr 1996;128:505
30. Kaplan BS, Kaplan P: Hemolytic uremic syndrome in families, in Kaplan BS, Trompeter RS, Moake JL (eds): The Hemolytic Uremic Syndrome and Thrombotic Thrombocytopenic Purpura. New York, Marcel Dekker, 1992, pp 213-226
31. Noris M, Ruggenenti P, Perna A, et al: Hypocomplementemia discloses genetic predisposition to hemolytic uremic syndrome and thrombotic thrombocytopenic purpura: Role of factor H abnormalities. J Am Soc Nephrol 1999;10:281
32. Gilbert RD, Argent AC: Streptococcus pneumoniae- associated hemolytic uremic syndrome. Pediatr Infect Dis J 1998;17:530
33. Cabrera GR, Fortenberry JD, Warshaw BL, et al: Hemolytic uremic syndrome associated with invasive Streptococcus pneumoniae infection. Pediatrics 1998;101:699
34. Moake JL: Thrombotic thrombocytopenic purpura today. Hosp Prac 1999;34:53
35. Furlan M, Robles R, Galbusera M, et al: Von Willebrand factor-cleaving protease in thrombotic thrombocytopenic purpura and the hemolytic uremic syndrome. N Engl J Med 1998;339:1578
36. Tsai H-M, Lian EC-Y: Antibodies to von Willebrand factor-cleaving protease in acute thrombotic thrombocytopenic purpura. N Engl J Med 1998;339:1585
A healthy 3 1/2-year-old girl visited a dairy farm with her family on July 20 and sampled raw milk. On July 23 she developed cramping abdominal pain and watery diarrhea. The following day she began vomiting and the diarrhea became frankly bloody. She was given an antimotility medication for her diarrhea.
The child's abdominal symptoms showed some improvement by July 28 and 29, but on July 30 she became listless and pale and did not void as much as usual. Her primary care physician ordered laboratory studies, which were significant for a WBC count of 40,000/µL with 85% neutrophils, hematocrit 25%, platelet count 78,000/µL, fragmented RBCs on the peripheral blood smear, blood urea nitrogen (BUN) 35 mg/dL, and creatinine 0.8 mg/dL. Hemolytic uremic syndrome was diagnosed, and the girl was admitted to the hospital for observation.
Over the next 24 hours she became anuric with a BUN of 55 mg/dL, creatinine 1.5 mg/dL, hematocrit 19%, and platelet count 30,000/µL. Her condition continued to deteriorate. Stools again became bloody and her abdomen became rigid. She was taken to surgery and found to have a gangrenous colon requiring colectomy.
On August 1 and 2, the child's hematocrit and platelet counts continued to decrease dramatically, accompanied by oozing of blood from IV and surgical sites, despite transfusion of packed RBCs and platelets. Her blood glucose was 420 mg/dL, and an insulin infusion was started. She also became hypertensive with blood pressures measuring in the 160/100 mm Hg range and was given antihypertensive medications. Hemodialysis was started to manage progressive uremia and volume overload related to the large quantities of blood products required to maintain her hematologic parameters.
During this time she also developed hallucinations, then focal seizures and was placed on mechanical ventilation to protect the airway. Cardiovascular collapse ensued requiring multiple pressor agents to maintain her blood pressure. She ultimately became frankly comatose with evidence of extensive cerebral infarction on imaging studies. On August 6 the girl met brain death criteria and was removed from life support.

This activity has been planned and implemented in accordance with the Essentials and Standards of the Accreditation Council for Continuing Medical Education through the joint sponsorship of Jefferson Medical College and Medical Economics, Inc.
Jefferson Medical College of Thomas Jefferson University, as a member of the Consortium for Academic Continuing Medical Education, is accredited by the Accreditation Council for Continuing Medical Education to sponsor continuing medical education for physicians. All faculty/authors participating in continuing medical education activities sponsored by Jefferson Medical College are expected to disclose to the activity audience any real or apparent conflict(s) of interest related to the content of their article(s). Full disclosure of these relationships, if any, appears with the author affiliations on page 1 of the article.
This CME activity is designed for practicing pediatricians and other health-care professionals as a review of the latest information in the field. Its goal is to increase participants' ability to prevent, diagnose, and treat important pediatric problems.
Jefferson Medical College designates this continuing medical educational activity for a maximum of one hour of Category 1 credit towards the Physician's Recognition Award (PRA) of the American Medical Association. Each physician should claim only those hours of credit that he/she actually spent in the educational activity.
This credit is available for the period of September 15, 2000, to September 15, 2001. Forms received after Septembert 15, 2001, cannot be processed.
Although forms will be processed when received, certificates for CME credits will be issued every four months, in March, July, and November. Interim requests for certificates can be made by contacting the Jefferson Office of Continuing Medical Education at 215-955-6992.
1. Each CME article is prefaced by learning objectives for participants to use to determine if the article relates to their individual learning needs.
2. Read the article carefully, paying particular attention to the tables and other illustrative materials.
3. Complete the CME Registration and Evaluation Form below. Type or print your full name and address in the space provided, and provide an evaluation of the activity as requested. In order for the form to be processed, all information must be complete and legible.
4. Send the completed form, with $20 payment if required (see Payment, below), to:
Office of Continuing Medical Education/JMC
Jefferson Alumni Hall
1020 Locust Street, Suite M32
Philadelphia, PA 19107-6799
5. Be sure to mail the Registration and Evaluation Form on or before September 15, 2001. After that date,
this article will no longer be designated for credit and forms cannot be processed.
Jefferson Medical College, in accordance with accreditation requirements, asks the authors of CME articles to disclose any affiliations or financial interests they may have in any organization that may have an interest in any part of their article. The following information was received from the author of "Hemolytic uremic syndrome: Reducing the risks."
William S. Varade, MD, has nothing to disclose.

William Varade. Hemolytic uremic syndrome: Reducing the risks. Contemporary Pediatrics 2000;9:54.
Access practical, evidence-based guidance to support better care for our youngest patients. Join our email list for the latest clinical updates.